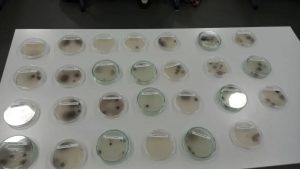

В 3 «Г» классе прошёл необычный урок по теме: «Бактерии в нашей жизни».
Этот урок был посвящён бактериям: их изучению, роли в природе и влиянию на человеческую жизнь. Учащиеся познакомились с видами бактерий и выяснили какие из них могут быть полезными, а какие вредными.
Урок проходил в два этапа:
1) ученики 10 «Б» класса взяли смывы с рук у ребят 3 «Г», данные смывы были помещены в чашки Петри с питательной средой;
2) через 2 недели мы предложили ребятам посмотреть, что выросло в ходе эксперимента.
Мы пригласили их в кабинет биологии и с помощью микроскопа из оборудования «Точки роста» увидели микроорганизмы, которые выросли в этих средах.
В конце урока сделали вывод, что необходимо следить за чистотой своих рук и всегда соблюдать правила гигиены.
Мероприятие проводили Фомичёва О. С., учитель биологии и химии и ученики 10 «Б» класса при поддержке Сериковой Н. С. , учителя биологии, и Масловой О. В., классного руководителя 3 «Г» класса.
Фото и информация Фомичёвой О.С.